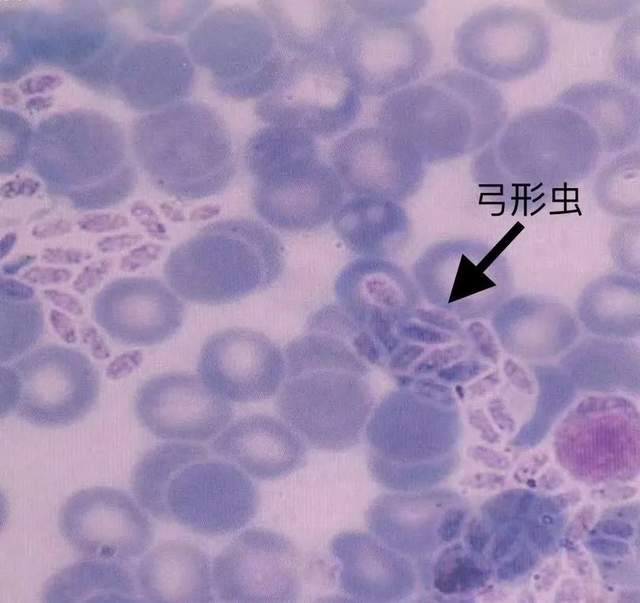

大家了解”弓形虫“吗?


一、弓形虫生活史
弓形虫是一种寄生虫,有其特殊的生活规律,这也决定了其传播途径不同于细菌或病毒。
滋养体:是弓形虫的增殖形式,分细胞内型与游离型两类,在急性感染机体内自行繁殖,在中间宿主与终宿主体内均可出现。急性感染期滋养体在宿主细胞内繁殖,内含数十个甚至上百个虫体。这种虫体的外膜是被宿主细胞包围而形成的,并非是原虫的分泌所形成的,所以称为假包囊。假包囊破裂后散发出的虫体为内殖子,又称为速殖子。
包囊:是感染的主要形式,在中间宿主和终宿主体内都可以出现,常在慢性感染动物的脑、肌肉等组织内形成,囊内含有数百甚至数千个虫体。包囊可以长期存活于组织内,甚至伴随宿主的一生。包囊在一定条件下会破裂,虫体溢出成为囊殖子,在组织内繁殖成为新的包囊。
卵囊:仅在终宿主内出现。未成熟的卵囊包含有一个孢子囊,成熟卵囊含有两个孢子囊。每个孢子囊含有4个子孢子。
裂殖体:子孢子进入终宿主小肠粘膜上皮细胞后,配子生殖开始前,虫体通过内二芽殖、内多芽殖、裂体增殖等进行增殖,最终成为多个虫体即裂殖子。裂殖体破裂后,裂殖子侵入到新的宿主细胞内,继续增殖为下一代裂殖体。
配子体:是弓形虫裂殖子侵入终宿主小肠粘膜上皮细胞后,未形成裂殖体,而发育为大、小两种配子体。小配子发育成熟后形成12~32个雄配子。
弓形虫具有双宿主生活周期,分别在肠外和肠内两个阶段内发育:
在肠外阶段发育时系无性繁殖:在各种中间宿主(如哺乳动物和鸟类)与终宿主(猫和猫科动物)组织内发育。 在肠内阶段的发育中,既有无性繁殖,又有有性繁殖:但仅在终宿主小肠粘膜上皮细胞内发育,在猫和猫科动物体内可以完成全部生活史,但是在猫科以外的动物及人体内则只进行无性繁殖。
全部生活史分5期:即滋养体期、包囊期、裂殖体期、配子体期和卵囊期。前3期是无性繁殖,后2期是有性繁殖。无性繁殖可造成全身感染,而有性繁殖则在肠粘膜形成局部感染。
弓形虫的滋养体是其致病状态;包囊为潜伏状态;囊合子仅存于宿主猫体内。
人类感染弓形虫,有两个途径:一是接触了病猫的粪便感染,二是食用了含有包囊的感染动物的肉(如未煮熟的羊肉、猪肉、鸟肉)等感染。
二、医学定论
人体是由细胞构成的,如果每个细胞是健康的,人一定是健康的,如果构成人体的细胞里有寄生虫,那么人就一定不会100%健康。
三、弓形虫的新理论
人类并没有满足于在细胞水平上对自身的认识,越来越多的科学家梦想有朝一日能清晰的看看细胞里面究竟隐藏着什么?
弓形虫检测试剂的诞生,证实了弓形虫的存在。在细胞接触本品后,我们可以惊讶的发现在全世界90%以上的人体有核细胞内都寄生着大量的弓形虫,它们隐秘的藏在人的大脑、心脏、眼底以及各大系统的组织的细胞内并大量繁殖,周期性扩散,与人体争夺营养,并在人体各组织内和血液中排泄毒素、废物,破坏免疫细胞,使人失去免疫功能。
这一重大科研成果的诞生,揭开了神童之谜,并用新的视角重新解释了人体十一腺体和九大系统的病因。我国著名中医专家,原西安医科大学创建人邢昭州先生在治疗弓形虫的论语中写到:
“人类生食的时代食入的是弓形虫活体、包囊体,对人的大脑有很大的破坏作用。 当人类熟食后,食入的是弓形虫的防护体及较少的活体,对人的大脑破坏就减少了,人的智力就得到了较大的提高,才有了今天的科学进步。”
如果从现在开始,人类用科学的办法清除大脑中的三尸虫(弓形虫)。则人类的大脑将得到空前的发展。如果说人类熟食是脑力发展的第一阶段,是从猿到人起决定作用的一步,是人类进化史上的一个里程碑,那么三尸虫(弓形虫)的消灭,便是人类脑力发展的第二个里程碑。
四、万病之源——弓形虫
可以说糖尿病、甲亢等内分泌疾病及心脑血管疾病有80%是弓形虫引起的;神经衰弱,神经官能症,多动症,强迫症,抑郁症,帕金森综合症,精神分裂症,老年脑萎缩等神经系统疾病有90%是弓形虫引起的;肾虚、腰酸背痛、骨质疏松、骨质软化及各种慢性病、疑难病有90%是弓形虫引起的。它寄生在人体有核细胞内,千百年来没人能够给予好的治疗方案。
弓形虫虽小,但是它的危害极大,且数量非常多,数以万亿计的弓形虫滋养体和包囊寄生在人体内。繁殖力特别强,每4.85个小时繁殖一次。
五、弓形虫的特征
1.生物学特性
a.人体内所有的有核细胞都可以寄生
b.80%寄生在大脑、其次是心肌、晶体及全身
c.无性和有性繁殖,以寄生态和致病态交替存在
d.借各种吞噬细胞到达全身各个部位
e.一旦感染终身携带
f.病源三性(寄生虫性、病菌性、病毒性)
g.免疫三性(抗原性、非抗原性、免疫迟后性)
h.顽固性,所有西药对它不起任何作用
2.病理学特性
机械破坏性致病、占位性致病、营养消耗性致病、毒素致病、免疫紊乱性致病。影响人的寿命、智商、出生缺陷、健康。
3.感染率极高的理论
4.弓形虫的破坏性
a.破坏免疫系统即破坏生命,吞噬生命,使人不能达到自然寿命;
b.干扰、破坏脑细胞影响人的智力:
①.弓形虫在大脑神经细胞中运动,使人注意力无法集中或无法清晰记忆;
②.将原已贮存记忆的脑神经细胞破坏而造成某段记忆消失;
③.阻断提取记忆的通路,使已记住的知识无法提取。
c.能穿透胎盘,破坏胎儿大脑,造成胎儿 畸形、出生缺陷、死胎等严重后果。
d.弓形虫80%寄生在大脑神经细胞,其次是晶体内部的细胞、心肌细胞以及全身各组织的细胞内。由于弓形虫的寄生,使人的综合免疫功能下降,给各种病源微生物的侵犯造成了机会,即能直接致病又能间接致病。
按中医理论: 弓形虫食人之精神气血,久之则体发虚,体虚者则易被七情六淫所伤,固为万病之源。实践证明:弓形虫破坏人体十一腺体和九大系统,是多种疾病的病源微生物,只要消灭弓形虫,很多的慢性病可以自愈。
六、弓形虫理论的应用 (人类四大工程)
1.指导长寿工程:通过杀灭人体组织细胞内的弓形虫,可以使人的寿命有一个很大的提高。
2.指导智力开发工程:通过消灭人体组织细胞内的弓形虫,可以使人的智商有很大的提高。
3.指导优生优育工程:只有消灭弓形虫,才能彻底解决出生缺陷问题。
4.临床指导:对于一般常见病治疗弓形虫可以提高免疫功能,让人不发病和少发病;对于诸多疑难病、慢性病,治疗弓形虫属于对因疗法。